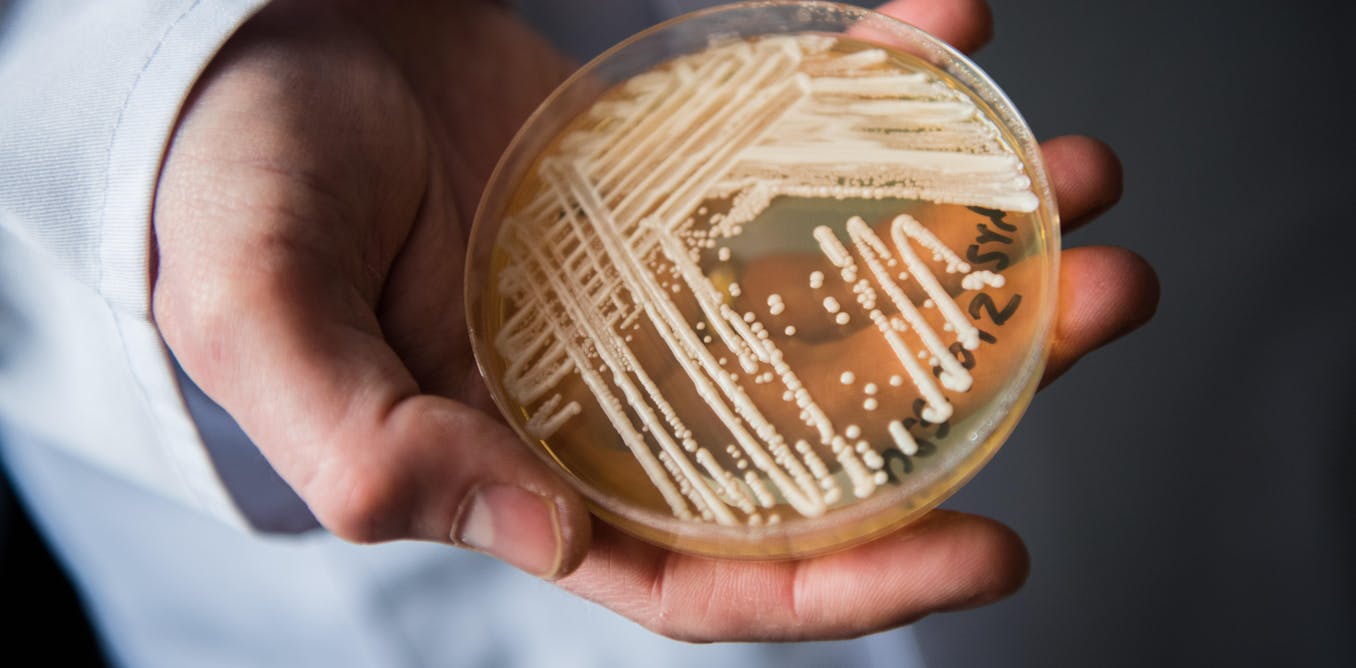
https://images.theconversation.com/files/517909/original/file-20230328-22-th38o.jpg?ixlib=rb-1.1.0&rect=0%2C738%2C6016%2C3008&q=45&auto=format&w=1356&h=668&fit=crop

Drug-Resistant , Hospital Acquired Fungal Pathogen
"[They're not] thermo-tolerant. They don't grow well in hot conditions and by hot, I mean body temperatures, like us. Like, 37 degrees [Celsius].""Fungi are an entire kingdom of life of their own. They're quite distinct from other organisms.""[They're microscopic, in many cases] except when they come up as mushrooms.""They consist of everything from yeast that raise bread and make beer, to moulds and mildews and all the terrible things that affect our crop plants.""[But they're also] fantastic chemists. They make such amazing molecules. [Penicillin comes from a fungus; the antibiotic era was launched out of the discovery of penicillin].""It probably jumps onto your skin first. You can imagine, especially if you're in a hospital, where there's lots of lines into you, and you're being poked and prodded a lot, it creates an opportunity for the skin to break and the fungus to get in."Professor Gerry Wright, Department of Biochemistry and Biomedical Sciences, McMaster University
![]() |
| Also concerning was a tripling in 2021 of drug-resistant cases. Photograph: Shawn Lockhart/AP |
The name of the fungus that is causing such consternation for its lethality and its future spread considered a new and burgeoning "urgent threat" to humans is candida auris. Unlike most fungi that affect humans this one is able to reproduce in warm-blooded bodies and it is "intrinsically resistant" to multi antifungal drugs. Candida auris has alarmed American hospitals where it has been spreading at an alarming rate. According to the U.S. Centers for Disease Control and Prevention, candida auris cases tripled between 2020 and 2021,
People who are extremely ill or who are immunocompromised represent those at increased risk of acquiring C. auris; generally it does not represent a health threat to healthy people. Its death rate is 28 to 53 percent, According to the World Health Organization. Canada's Public Health Agency has reported a total of 43 cases. In the U.S. the total is 4,041.
Professor Wright has focused on the study of fungi for the past 40 years, beginning when the HIV crisis was peaking. "Folks were dying", because their collapsing immune systems were unable to fend off "opportunistic" infections such as fungal infections. Candida Auris is a form of yeast first discovered in 2009 in Japan, when a 70-year-old-woman's ear canal was found to be hosting the fungus. Infections of the blood, heart, central nervous system, eyes, bones and internal organs can be caused by the organism.
| Candida auris, CDC |
Candida Auris has been found on sinks in hospitals, on bed rails, on curtains and floors "where it can persist for up to a month", according to the University of Minnesota Centers for Infectious Disease Research and Policy. "Right now this is not something that people walking down the street should be frightened of", cautions Professor Wright. Those with weak immune systems and hospital patients with "indwelling" medical devices such as ventilators and catheters are the most vulnerable.
"We really didn't know anything about candida auris until the first report [in 2009]. But almost simultaneously, it was discovered pretty much all around the world, and it sort of emerged all at once", explained Professor Wright. According to one hypothesis, as the world's temperature increased, the fungus adapted to survive in warmer environments "and that provided it with an opportunity to infect humans", stated Dr. Wright. In the mid-1980s once antiretroviral drug cocktails became "groundbreakingly" effective against HIV, invasive fungal infections were reduced in number to a dramatic extent.
And now, Professor Wright believes the time is right to take infectious diseases as seriously as medical science takes chronic diseases like diabetes and cancer. Complacency surrounding infectious diseases because of vaccines and antibiotics has led medical science to neglect the need to focus on research that will prepare the world for ever greater numbers of emerging pathogens and the steps needed to deal with their presence either through cures, new vaccines or therapies that can prolong life, not the pathogens.
![]() |
| dpa picture alliance/Alamy Stock Photo |
"This is like the genie out of the bottle. These bugs are here,they're in our hospital systems, they're in our long-term care facilities. They're not going to get any easier to treat.""We don't know how bad it's going to be, but people are going to die, and we need to be aware of it and find ways to detect it in the first place, but also to treat it.""...If you're in a long-term care facility it's unlikey that you're going to be able to detect it until there's an outbreak. It's not routinely looked for. It might be in the future, as this starts to grow.""[The result:] You have this sort of almost perfect storm. You don't have a lot of drugs available to treat a fungal infection in the first place, you've got a pathogen that has evolved the ability to infect us because it's learned how to live at higher temperatures, and that fungus happens to be intrinsically drug-resistant to begin with."Professor Gerry Wright
Labels: Biochemistry, Biomedical Sciences, Candida Auris, Fungal Infections, Hospitals, Immunocompromised, Long-Term Care Facilities

0 Comments:
Post a Comment
<< Home